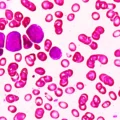
Kako je nanotehnologija učinila stari lek za leukemiju 22.000 puta jačim

Uzroci noćnog buđenja i kako ponovo zaspati
Buđenje u 3 sata ujutru i nemogućnost da ponovo zaspite može biti veoma frustrirajuće. Ovo stanje, poznato kao noćno buđenje ili rano jutarnje buđenje, zapravo je prilično često.
Jedno američko istraživanje pokazalo je da se više od trećine ljudi budi usred noći najmanje tri puta nedeljno.
Ali zašto se to dešava?
🛏️ 1. Smetnje iz okoline
Tokom noći naš san prolazi kroz različite faze — od dubokog sna do lakšeg sna. Kako se približava jutro, više vremena provodimo u lakšim fazama sna, pa se lakše budimo.
Najčešći spoljašnji okidači su:
- 🚗 buka sa ulice
- 📺 televizor ili telefon
- 💡 svetlo koje dopire kroz prozor
- čak i slaba noćna lampica
U ranim jutarnjim satima organizam je podložniji buđenju iz tih razloga.
🚻 2. Odlazak u toalet (noćno mokrenje)
Buđenje zbog potrebe za mokrenjem naziva se nokturiја.
Uzroci mogu biti:
- unošenje tečnosti kasno uveče
- kafa ili alkohol
- problemi sa bešikom
- opstruktivna apneja u snu
- dijabetes
- trudnoća
Kod starijih osoba ovo je posebno česta pojava.

🔥 3. Menopauza
Hormonalne promene tokom menopauze često uzrokuju:
- noćna znojenja
- valunge
- nesanicu
- rano jutarnje buđenje
Ove tegobe ponekad mogu trajati i nakon završetka menopauze.
😴 4. Poremećaji spavanja
Noćna buđenja mogu biti simptom određenih poremećaja:
Nesanica
Teškoće sa održavanjem sna, posebno ako budnost traje duže od 30 minuta.
Opstruktivna apneja u snu
Kratkotrajni prekidi disanja tokom sna mogu probuditi osobu.
Poremećaji cirkadijalnog ritma
Unutrašnji biološki sat nije usklađen sa spoljnim vremenom.
Noćne more
Često se javljaju u drugoj polovini noći i otežavaju ponovno uspavljivanje.
😟 5. Stres, anksioznost i depresija
Psihološki faktori su među najčešćim uzrocima buđenja u 3 ujutru.
Stres može izazvati:
- preterano razmišljanje
- nemogućnost opuštanja
- povišenu budnost
Osobe sa posttraumatskim stresnim poremećajem, paničnim poremećajem ili depresijom često imaju poremećen san.
Depresija posebno utiče na unutrašnji biološki sat, pa osoba može osećati budnost u vreme kada bi trebalo da spava.
🩺 6. Zdravstvena stanja i lekovi
Brojna zdravstvena stanja povezana su sa noćnim buđenjem:
- hronični bol
- visok krvni pritisak
- bolesti srca
- astma i HOBP
- dijabetes
- problemi sa štitnom žlezdom
- neurološka oboljenja (demencija, Parkinsonova bolest)
Neki lekovi, poput diuretika i kortikosteroida, takođe mogu izazvati buđenje.
👵 7. Starenje
Sa godinama:
- smanjuje se dubok san
- cirkadijalni ritam se pomera
- češće dolazi do buđenja
Starije osobe se mogu buditi tri do četiri puta tokom noći, što je relativno uobičajeno.
🌿 Kako spavati neprekidno kroz noć?
Evo nekoliko saveta koji mogu pomoći:
☕ Izbegavajte kofein i alkohol uveče
Oba mogu poremetiti san i povećati potrebu za mokrenjem.
🌞 Povećajte izlaganje dnevnom svetlu
Sunčeva svetlost tokom dana pomaže regulaciji biološkog sata.
🧘 Vežbajte ili probajte jogu
Redovna fizička aktivnost poboljšava kvalitet sna.
🍽️ Ne jedite kasno
Izbegavajte obroke tri sata pre spavanja.
🌑 Održavajte spavaću sobu tamnom i tihom
Maska za oči i čepići za uši mogu biti korisni.
📌 Kada potražiti pomoć?
Obratite se lekaru ako:
- buđenje traje duže vreme
- osećate dnevni umor
- imate simptome apneje u snu
- primetite promene raspoloženja
🌙 Zaključak
Buđenje u 3 ujutru je često i u većini slučajeva nije razlog za brigu. Uzroci mogu biti jednostavni — poput buke ili kasne večere — ali ponekad ukazuju na stres ili zdravstveni problem.
Razumevanje uzroka prvi je korak ka boljem i mirnijem snu.
Ako se problem nastavi, stručni savet može pomoći da ponovo uživate u neprekidnom odmoru. 😴